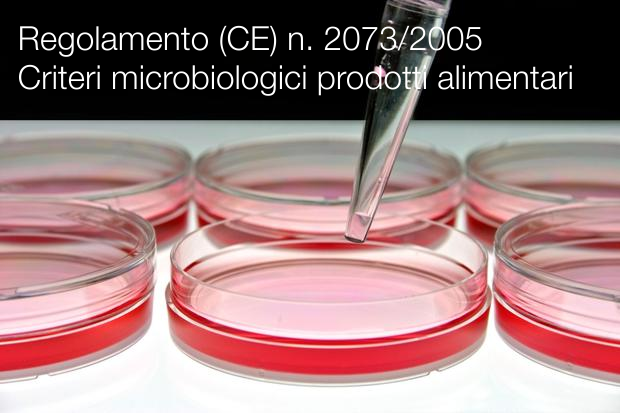
Regolamento CE n 2073 2005 Criteri microbiologici prodotti alimentari Regolamento CE n 2073 2005 Criteri microbiologici prodotti alimentari

Regolamento (CE) n. 2073/2005
| ID 7904 | | Visite: 70506 | Legislazione HACCP | Permalink: https://www.certifico.com/id/7904 |
Regolamento (CE) n. 2073/2005 / Criteri microbiologici prodotti alimentari
Regolamento (CE) n. 2073/2005 della Commissione del 15 novembre 2005 sui criteri microbiologici applicabili ai prodotti alimentari
(GU L 338/1 del 22.12.2005)
_______
Articolo 1 Oggetto e campo d’applicazione
Il presente regolamento stabilisce i criteri microbiologici per taluni microrganismi e le norme di attuazione che gli operatori del settore alimentare devono rispettare nell’applicazione delle misure di igiene generali e specifiche di cui all’articolo 4 del regolamento (CE) n. 852/2004.
L’autorità competente verifica il rispetto delle norme e dei criteri di cui al presente regolamento conformemente al regolamento (CE) n. 882/2004, senza pregiudizio del suo diritto di procedere a ulteriori campionamenti ed analisi per la rilevazione e la misura della presenza di altri microrganismi, delle loro tossine o dei loro metaboliti, o come verifica dei processi, per i prodotti alimentari sospetti, o nel contesto dell’analisi del rischio. Il presente regolamento si applica senza pregiudizio di altre norme specifiche relative al controllo dei microrganismi stabilite dalla legislazione comunitaria e in particolare degli standard sanitari per i prodotti alimentari stabiliti dal regolamento (CE) n. 853/2004 del Parlamento europeo e del Consiglio, delle norme sui parassiti fissate dal regolamento (CE) n. 854/2004 del Parlamento europeo e del Consiglio e dei criteri microbiologici di cui alla direttiva 80/777/CEE del Consiglio.
Articolo 3 Prescrizioni generali
1. Gli operatori del settore alimentare provvedono a che i prodotti alimentari siano conformi ai relativi criteri microbiologici fissati nell’allegato I del presente regolamento. A tal fine, gli operatori del settore alimentare adottano provvedimenti, in ogni fase della produzione, della lavorazione e della distribuzione, inclusa la vendita al dettaglio, nell’ambito delle loro procedure HACCP e delle loro prassi corrette in materia d’igiene, per garantire che:
a) la fornitura, la manipolazione e la lavorazione delle materie prime e dei prodotti alimentari che dipendono dal loro controllo si effettuino nel rispetto dei criteri di igiene del processo;
b) i criteri di sicurezza alimentare applicabili per l’intera durata del periodo di conservabilità dei prodotti possano essere rispettati a condizioni ragionevolmente prevedibili di distribuzione, conservazione e uso.
2. Se necessario, gli operatori del settore alimentare responsabili della fabbricazione del prodotto effettuano studi, in conformità all’allegato II, per verificare se i criteri sono rispettati per l’intera durata del periodo di conservabilità. In particolare ciò si applica agli alimenti pronti che costituiscono terreno favorevole alla crescita di Listeria monocytogenes e che possono costituire un rischio per la salute pubblica in quanto mezzo di diffusione di tale batterio.
Gli operatori del settore alimentare possono condurre gli studi suddetti in collaborazione tra loro.
Linee guida per la realizzazione di tali studi possono essere incluse nei manuali di buona prassi igienica di cui all’articolo 7 del regolamento (CE) n. 852/2004.
___________
Modificato da:
- M1 Regolamento (CE) n. 1441/2007 della Commissione del 5 dicembre 2007
- M2 Regolamento (UE) n. 365/2010 della Commissione del 28 aprile 2010
- M3 Regolamento (UE) n. 1086/2011 della Commissione del 27 ottobre 2011
- M4 Regolamento (UE) n. 209/2013 della Commissione dell’11 marzo 2013
- M5 Regolamento (UE) n. 1019/2013 della Commissione del 23 ottobre 2013
- M6 Regolamento (UE) n. 217/2014 della Commissione del 7 marzo 2014
- M7 Regolamento (UE) 2015/2285 della Commissione dell'8 dicembre 2015
- M8 Regolamento (UE) 2017/1495 della Commissione del 23 agosto 2017 - Testo consolidato 01.01.2018
- M9 Regolamento (UE) 2019/229 della Commissione del 7 febbraio 2019
- M10 Regolamento (UE) 2020/205 della Commissione del 14 febbraio 2020 - Testo consolidato 08.03.2020
Rettificato da:
Rettifica, GU L 278, 10.10.2006, pag. 32 (2073/2005)
Rettifica, GU L 068, 13.3.2015, pag. 90 (1086/2011)
Rettifica, GU L 195, 20.7.2016, pag. 82 (1441/2007)
Rettifica, GU L 195, 20.7.2016, pag. 83 (n. 1019/2013)
...
Collegati:
| Descrizione | Livello | Dimensione | Downloads | |
|---|---|---|---|---|
| Regolamento CE n. 2073 2005 Testo consolidato 01.01.2018.pdf |
426 kB | 48 |